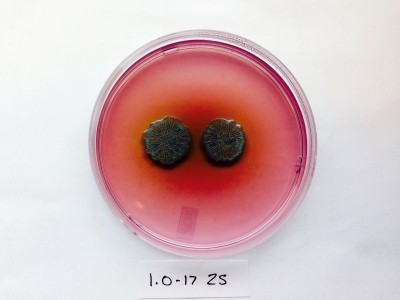

About
Welcome to the Experimental Molecular Evolution lab website at Carleton University. We are interested in microbial genomics and evolution, with strengths in antimicrobial resistance, experimental evolution, and surveillance. Please check out our research, photos, and recent news.